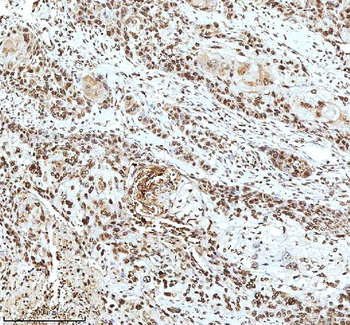
Histone H3 HIST1H3A/B/C/D/E/F/G/H/I/J Antibody

You have no items in your shopping cart.
- CD206 antibody [orb4941]Featured

ELISA, ICC, IF, IHC-P, WB
Rabbit
Polyclonal
Unconjugated
1 mg, 200 μg, 100 μg - Musashi 1/Msi1 Antibody [orb19089]
FC, ICC, IF, IHC, WB
Human, Mouse, Rat
Rabbit
Polyclonal
Unconjugated
100 μg - Goat Rabbit IgG(H+L) Antibody, FITC conjugated [orb688925]Featured

FC, IF, IHC
Rabbit
Goat
Polyclonal
FITC
300 μl - Histone H3 HIST1H3A/B/C/D/E/F/G/H/I/J Antibody [orb614120]
ELISA, FC, ICC, IF, IHC, WB
Human, Mouse, Rat
Rabbit
Polyclonal
Unconjugated
100 μg - Vimentin Rabbit Polyclonal Antibody [orb11559]Featured

FC, ICC, IF, IHC-Fr, IHC-P, WB
Human, Mouse, Rat
Bovine, Gallus, Goat, Porcine
Rabbit
Polyclonal
Unconjugated
100 μl, 200 μl, 50 μl - TGF beta 1 antibody [orb11468]Featured

ELISA, ICC, IF, IHC-P, WB
Rabbit
Polyclonal
Unconjugated
100 μg, 15 μg